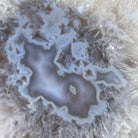

Polished Agate Crescent Moon on a Stand, 4.8 lbs & 11" Tall #5740NA-006
This is a Natural Polished Brazilian Agate Crescent Moon Druzy on a metal stand. With its polished edges and natural crystals shining through you'll enjoy this piece for years to come.
Artisans in South Brazil mastered the technique to make crescent moon shaped gemstones, a very labor-intensive task that requires a lot of skill and precision. The result is a beautiful piece that will certainly look great in your home or office or make a long lasting gift to a loved one.
- Overall Height in Stand: 11"
- Gemstone Size: 7.8"H x 6.7"W x 1.6"D
- Weight w/ Stand: 4.8 lbs
Disclaimer: This is a natural gemstone crystal sold as is and as you see it in its images and video. It is the exact one you will receive. It may contain natural imperfections and/or imperfections, scratches, broken edges and repairs from the extraction, polishing, prepping and mounting processes. The metal base has been hand welded to fit this specific piece, then painted black. Light not included.
AGATE: Protection - Strength - Courage
Agate and its many shades can offer a talisman for courage through times of sunshine and shadow. It can offer protection and grounding energy, enhancing feelings of security. If you are in a season of worry or overthinking, Agate can invite healing energy to your inner world. Agate is formed in the cavities of ancient volcanic rocks. After the rock cools, microcrystal fibers collect as water pools or passes through. The layers build up over time, with different colors reflecting differences in the water’s composition. The result is a colorful reminder of the power of strength built with time.
Free Ground Shipping: All items ship directly from our warehouse in Southern California and we offer FREE ground shipping via FedEx Ground or USPS Ground Advantage to customers in the United States (restrictions apply to Alaska, Hawaii and US Territories). We process orders quickly to get your products to you as fast as possible, typically shipping out the same day or next business day. When selecting our Free Ground Shipping option, packages generally arrive in 2-7 business days, depending on the distance to your destination. Deliveries to areas near our Southern California warehouse may arrive faster (2-3 business days), while those traveling greater distances, such as to the East Coast, may require additional transit time (5-7 business days). Expedited shipping options, such as overnight delivery, are also available at an additional cost. Customers will be provided with tracking information to monitor their shipment’s progress.
Canada Shipping: We offer heavily discounted rates and in some cases free ground shipping on items up to 70 pounds (subject to Customs and Duty fees). Contact us directly via chat or send an email to info@brazilgems.com prior to purchase to check on shipping rates as it will depend on the item(s) selected. Expedited shipping options are also available at an additional cost.
Worldwide Shipping: We proudly ship worldwide, with pricing options displayed during checkout. Customers are responsible for any Customs, Duties, and/or VAT taxes levied by their country. Upon arrival, the shipping carrier will contact the customer to arrange payment of any applicable taxes to ensure successful delivery. As these fees are determined by local authorities and vary by destination, Brazil Gems is unable to provide specific tax amounts in advance.
Professional Packaging & Insurance: After years of experience, we have mastered the art of successfully shipping delicate products across the world. Your item will ship fully insured and protected. You can purchase with confidence.
This is a Natural Polished Brazilian Agate Crescent Moon Druzy on a metal stand. With its polished edges and natural crystals shining through you'll enjoy this piece for years to come.
Artisans in South Brazil mastered the technique to make crescent moon shaped gemstones, a very labor-intensive task that requires a lot of skill and precision. The result is a beautiful piece that will certainly look great in your home or office or make a long lasting gift to a loved one.
- Overall Height in Stand: 11"
- Gemstone Size: 7.8"H x 6.7"W x 1.6"D
- Weight w/ Stand: 4.8 lbs
Disclaimer: This is a natural gemstone crystal sold as is and as you see it in its images and video. It is the exact one you will receive. It may contain natural imperfections and/or imperfections, scratches, broken edges and repairs from the extraction, polishing, prepping and mounting processes. The metal base has been hand welded to fit this specific piece, then painted black. Light not included.
AGATE: Protection - Strength - Courage
Agate and its many shades can offer a talisman for courage through times of sunshine and shadow. It can offer protection and grounding energy, enhancing feelings of security. If you are in a season of worry or overthinking, Agate can invite healing energy to your inner world. Agate is formed in the cavities of ancient volcanic rocks. After the rock cools, microcrystal fibers collect as water pools or passes through. The layers build up over time, with different colors reflecting differences in the water’s composition. The result is a colorful reminder of the power of strength built with time.